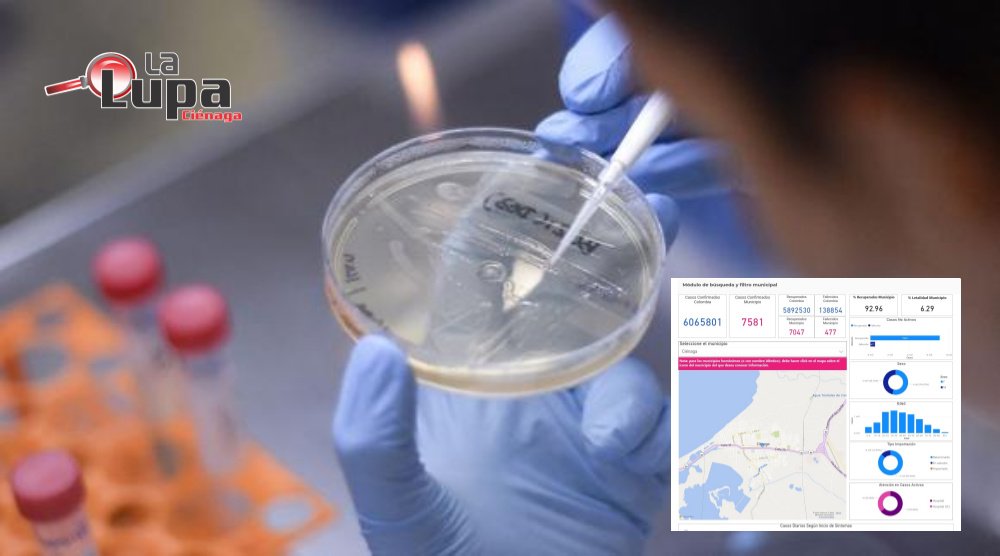

El más reciente informe del Instituto Nacional de Salud, indica que el martes 1ro de marzo se registró un sólo caso positivo Covid 19 en Ciénaga.
La cifra de diagnósticos confirmados pasó de 7.580 a 7.581.
477, es el número de muertes reportadas en Ciénaga durante la pandemia Covid 19.
En ese orden, el Instituto Nacional de Salud informó que el número de recuperados está en 7.047 (92.96%).
57 es el número de pacientes activos, con corte a 1ro de marzo de 2022.
Síguenos en la web: www.lalupacienaga.com.co